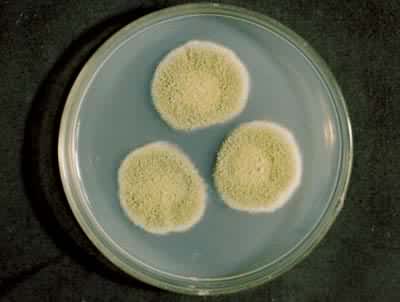

1) hui ching

灰青<灰蓝色料>
2) robin's egg blue

灰绿蓝色
3) regimental
[英][,redʒɪ'mentl] [美]['rɛdʒə'mɛntḷ]

灰紫蓝色
补充资料:灰黄青霉(Penicillium griseofulvum)
齐祖同提供
[图]
说明:补充资料仅用于学习参考,请勿用于其它任何用途。
参考词条